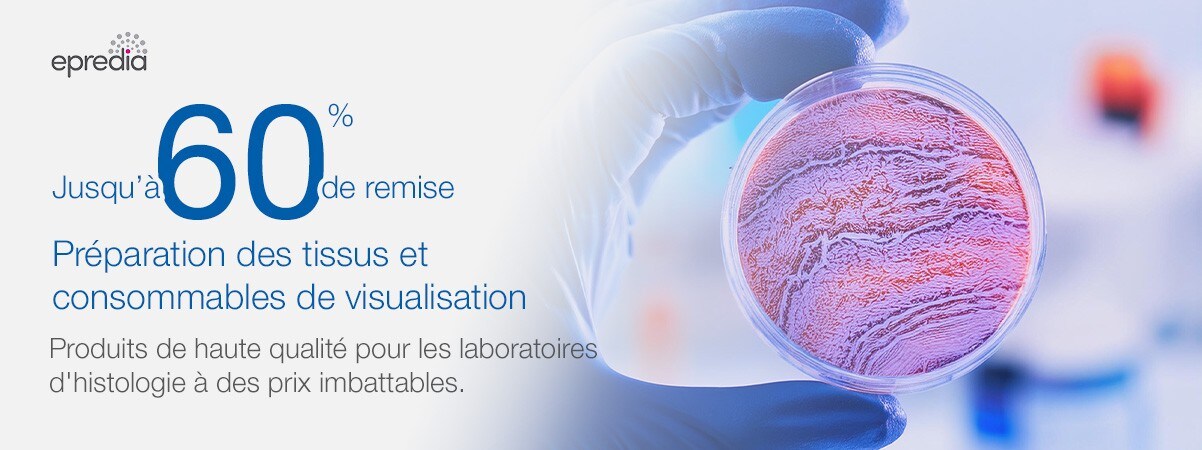
Epredia Epredia

Consommables pour la préparation et la visualisation des tissus
Améliorez votre efficacité en histologie avec jusqu'à 60 % de réduction sur les consommables de préparation et de visualisation des tissus
Découvrez des produits de haute qualité, testés en laboratoire, à des prix imbattables – Offre limitée dans le temps.
Les laboratoires d'histologie s'appuient sur la précision et la fiabilité, et nous sommes ici pour soutenir votre travail essentiel. Pendant une période limitée, profitez de jusqu'à 60 % de réduction sur notre large gamme de consommables pour la préparation et la visualisation des tissus. Que vous travailliez avec des techniques d'imagerie de pointe ou que vous perfectionniez vos flux de travail de traitement des tissus, nous avons tout ce dont vous avez besoin.
Utilisez le code promotionnel 21628 pour accéder aux prix spéciaux jusqu'au 31 octobre 2024.*